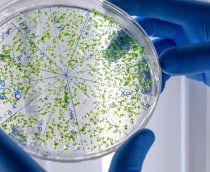
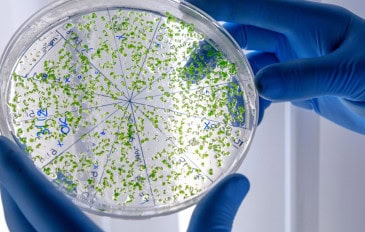

Ofertas

Vendido por Amazon
Teclado Gamer RGB LED Rainbow MTS • Membrana • Anti-Ghosting • ABNT-2 • USB-A • Multimídia FN 12 Teclas • Ideal para Jogos e Digitação • Setup Gamer • Elegante • Premium
De: R$ 52,99
Por: R$ 39,99
Por: R$ 39,99

Vendido por Amazon
Caixa de Som Boombox Plus AIWA BBS-01-LBL 200W BT 30H IP66 USB RGB
Por R$ 1.519,00

Vendido por Amazon
Razer Wolverine V3 Tournament Edition XBOX/PC, 6 Remappable Buttons to Outplay Them All, 1000Hz Polling Rate for Competitive Play on PC, Wired Esports Controller - Black
Por R$ 512,54

Vendido por Amazon
PISTOLA PARA COLA QUENTE PEQUENA UND LEOARTE
De: R$ 15,53
Por: R$ 11,90
Por: R$ 11,90

Vendido por Amazon
Marca Texto Pastel, Faber-Castel, MT/15466, Textliner Pastel 46, 6 Unidades
Por R$ 41,44

Vendido por Amazon
CIS, Caneta Esferografica 0,7 mm TIK Blister com 10 cores, 5AZ+3PT+2VM
De: R$ 23,99
Por: R$ 18,30
Por: R$ 18,30

Vendido por Amazon
Persona 3 Reload: Standard Edition - PlayStation 5
Por R$ 172,70

Vendido por Amazon
PHILIPS, Caixa de Som Bluetooth Party Speaker, com Luzes LED, TAX4209/78, FM, USB, Cartão SD, Auxiliar, TWS, Entradas Microfone/Guitarra
Por R$ 790,00

Vendido por Amazon
Celular Samsung Galaxy A07 256GB, 8GB, Câm. 50MP, Tela 6.7" - Preto
Por R$ 1.099,00

Vendido por Amazon
Monitor Gamer | Pichau Nexus 34 Neo | 34" Curvo VA Ultrawide WQHD 165Hz 1ms | FreeSync G-Sync | PG-NXS34NEO-BL02
Por R$ 1.425,90

Vendido por Amazon
Tablet Samsung Galaxy Tab A7, Wi-fi e 4G, 64GB, 3 GB RAM, Tela 10.4", Octa-Core, SM-T505NZAQZTO, Grafite
Por R$ 1.730,08

Vendido por Amazon
Smartphone Motorola Moto g05-256GB 12GB (4GB RAM + 8GB Ram Boost) e Camera 50MP com AI Bateria de 5200 mAh Tela 6.7" com Superbrilho - Verde
Por R$ 899,00

Vendido por Amazon
Smartphone Motorola Moto g05-256GB 12GB (4GB RAM + 8GB Ram Boost) e Camera 50MP com AI Bateria de 5200 mAh Tela 6.7" com Superbrilho - Grafite
Por R$ 899,00

Vendido por Amazon
Smartphone Motorola Moto g05-256GB 12GB (4GB RAM + 8GB Ram Boost) e Camera 50MP com AI Bateria de 5200 mAh Tela 6.7" com Superbrilho - Vermelho
Por R$ 899,00

Vendido por Amazon
100 Atividades Stitch
De: R$ 24,90
Por: R$ 12,45
Por: R$ 12,45

Vendido por Amazon
GameSir Nova Lite Controlador sem fio 2.4g para PC com Windows, iPhone, Android, Switch e Steam Deck, Controle Bluetooth Gamepad com gatilho de efeito Hall, Turbo, vibração Rumble(cor verde)
De: R$ 269,00
Por: R$ 174,85
Por: R$ 174,85

Vendido por Amazon
Webcams 4K Tiny 2 com controle de voz PTZ, rastreamento AI multimodo e foco automático, câmera web com sensor de 1/1,5", controle por gestos,OBSBOT 60 FPS, Adequado para go-pro/logi-tech/computador
De: R$ 2.200,00
Por: R$ 1.600,00
Por: R$ 1.600,00

Vendido por Amazon
Impressora HP OfficeJet 9730 Wide Format A3 Multifuncional Wireless com Gama de cores P3
De: R$ 2.220,89
Por: R$ 1.860,08
Por: R$ 1.860,08

Vendido por Amazon
Impressora Multifuncional Laser Mono Canon MF262DW
De: R$ 1.622,12
Por: R$ 1.300,72
Por: R$ 1.300,72

Vendido por Amazon
Fritadeira Elétrica sem oleo Electrolux Airfryer 4L 8 receitas pré-sugeridas desligamento automatico cesto removivel 1400W EAF30 grafite 127v
De: R$ 282,13
Por: R$ 226,54
Por: R$ 226,54

Vendido por Amazon
Ar condicionado janela 7500 BTUs Consul frio com design moderno - CCB07FB 110V
De: R$ 1.466,00
Por: R$ 1.299,00
Por: R$ 1.299,00

Vendido por Amazon
GameSir Super Nova Wireless Gaming Controller for PC/Switch/Switch 2/iOS/Android, 1000Hz Polling Rate, Hall Effect Stick & Trigger, Rubberized Grips, RGB Lighting, 1000mAh - Blue
De: R$ 459,00
Por: R$ 269,99
Por: R$ 269,99

Vendido por Amazon
Borderlands 3 Ultimate Edition
Por R$ 155,52

Vendido por Amazon
Apple iPhone 13 (128 GB) - Meia-noite
De: R$ 3.887,78
Por: R$ 3.299,00
Por: R$ 3.299,00

Vendido por Amazon
Fones de Ouvido QCY MeloBuds Pro, Fone Bluetooth com Cancelamento de Ruído Ativo, Certificação Hi-Res, 34 Horas De Reprodução, Dourado
De: R$ 299,00
Por: R$ 254,15
Por: R$ 254,15

Vendido por Amazon
Lampada Led Smart Inteligente Wi Fi Alexa google 10w RGB E27 110v/220v Cod: 290028177 Neo Avant (1)
De: R$ 28,90
Por: R$ 23,30
Por: R$ 23,30

Vendido por Amazon
FIFINE Microfone para jogos XLR/USB para podcasting, microfone RGB para computador PC, com botão de ganho, botão de mudo, conector de monitoramento, microfone para jogadores para gravação- AM8 Branco
De: R$ 344,00
Por: R$ 253,65
Por: R$ 253,65

Vendido por Amazon
Teclado Mecânico Gamer Razer Huntsman Mini - 60% Optical Linear Red Switch, Preto
De: R$ 1.839,90
Por: R$ 988,42
Por: R$ 988,42

Vendido por Amazon
QCY H3 PRO ANC Fone de Ouvido Bluetooth, Headphone ANC Adaptáveis, Cancelamento Ativo de Ruído de 50 dB, Áudio sem fio de Alta Resolução LDAC, 55 Horas de Reprodução, Preto (H3PRO-BLACK)
De: R$ 389,00
Por: R$ 330,65
Por: R$ 330,65